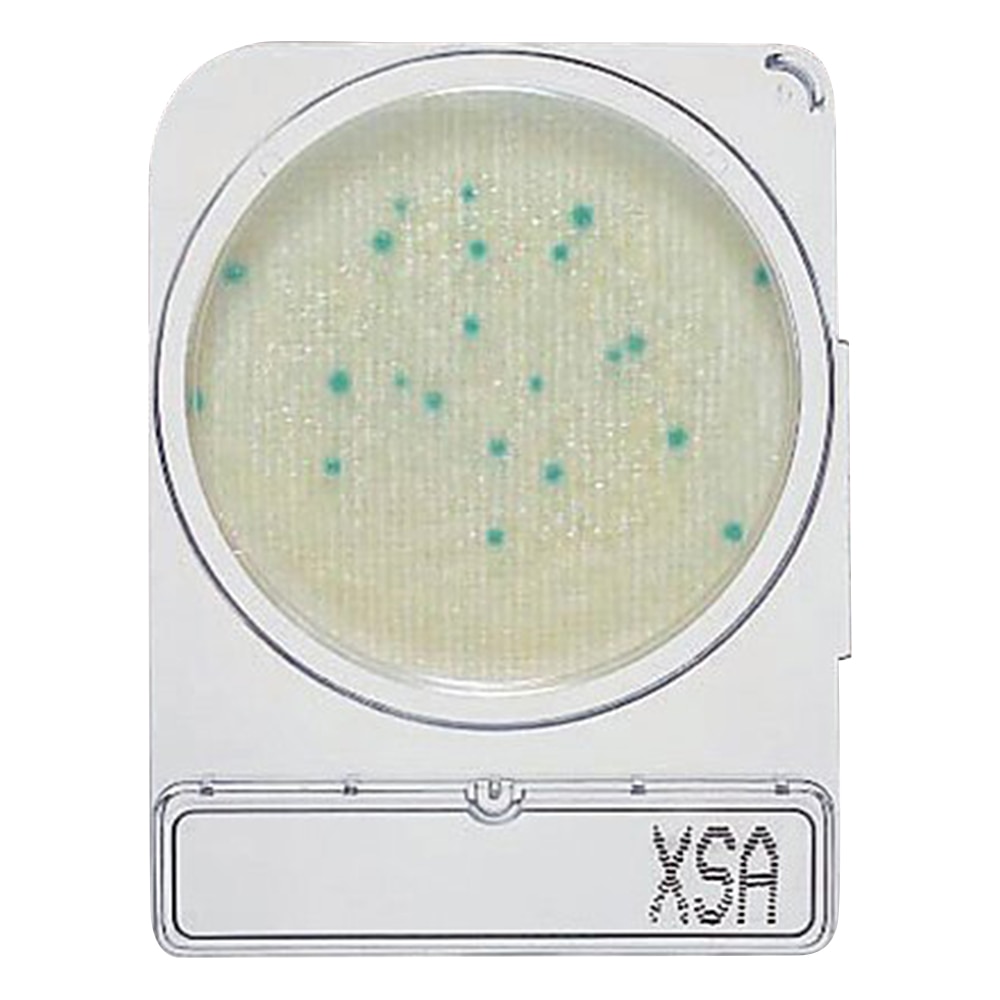
島津ダイアグノスティクス コンパクトドライ (黄色ブドウ球菌測定用/4枚×10袋) 06729 1箱(ご注文単位1箱)【直送品】

毎月第1・第3月曜日はシモパケDAY!商品全品3%OFF!

価格:¥9,240(税込)
価格(個単価): ¥9,240(税込)


沖縄・離島配送不可

返品不可・日曜祝日指定不可
●培地調製の不要な菌数測定用の培地です。●AOAC PTM(性能検証済み試験法)を取得しています。●接種した試料液は自然に均一に拡散します。●発育した集落は着色するため菌数の計測が容易です。●発育集落の釣菌が可能です。●●スマホでのコンパクトドライ専用コロニーカウントサービス「@BactLAB」を提供しています。詳細は「図面・資料」の案内をご確認ください。●γ線滅菌済(一括包装)●黄色ブドウ球菌測定用●入数:1箱(4枚/袋×10袋入)●※保存方法:1~30℃(常温)●※有効期限:製造より24ヶ月●※食品衛生検査指針 微生物編2018収載製品●こちらの商品は事業者様向け商品です。
商品名
価格(税込)
サイズ
発送元
レビュー
島津ダイアグノスティクス コンパクトドライ (黄色ブドウ球菌測定用/4枚×10袋) 06729 1箱(ご注文単位1箱)【直送品】
¥9,240
【直送品】アズワン

価格:¥4,422(税込)

価格:¥184(税込)

価格:¥387(税込)

価格:¥5,436(税込)

価格:¥739(税込)

価格:¥43,120(税込)

価格:¥12,923(税込)

価格:¥44,085(税込)

価格:¥286(税込)

価格:¥330(税込)

価格:¥565(税込)
※ご注文後、在庫がない場合キャンセル等のご連絡をさせていただきます。